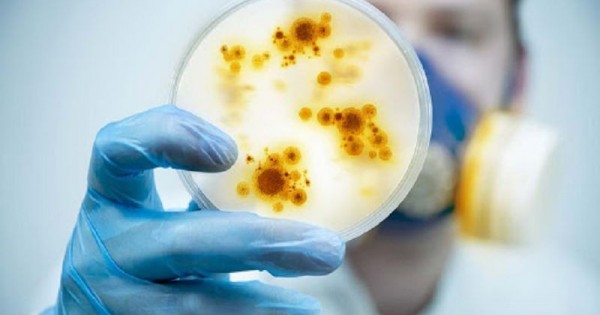

– 1994 جىلى ءۇندىستاندا وبانىڭ وكپە ارقىلى تارايتىن وتە قاۋىپتى ءتۇرى پايدا بولدى, – دەيدى بىزبەن اڭگىمەسىندە مەديتسينا عىلىمدارىنىڭ دوكتورى, پروفەسسور, 2009-2011 جىلدار ارالىعىندا دەنساۋلىق ساقتاۋ مينيسترلىگى مەملەكەتتىك سانيتارلىق-ەپيدەميالىق باقىلاۋ كوميتەتىنىڭ توراعاسى – باس مەملەكەتتىك سانيتارلىق دارىگەر قىزمەتىن اتقارعان كەڭەس وسپانوۆ. – ارنايى مالىمەتتەرگە قاراعاندا ءۇندىستاندا سول جىلى وسى ىندەتكە بايلانىستى 693 دەرەك تىركەلگەن. كارانتين 1994 جىلدىڭ 26 تامىزىنان 18 قازانىنا دەيىن سوزىلدى. شىنىن ايتۋ كەرەك, بۇل ىندەتتەن دۇنيە ءجۇزى ەسىنەن تانىپ قالدى. بارلىق ەل ۇندىستانمەن بارىس-كەلىستى بىردەن توقتاتتى. ۇشاق رەيستەرىنىڭ ءبارى اۋىستىرىلدى. كەيىننەن بۇل اۋرۋ ءۇي تىشقاندارى ارقىلى تاراعانى بەلگىلى بولدى. ەڭ قاۋىپتىسى, جۇرت اراسىندا اۋرۋ جۇقتىرىپ الامىن دەگەن ۇرەي باستالىپ, ءۇندىستاننىڭ سۋرات دەگەن قالاسىنان ەكى كۇندە 300 مىڭ ادام قاشىپ شىققان. قازىرگى پاندەميادا جۇرتتى وقشاۋلاپ ۇلگەردى عوي. ال ول كەزدە وقشاۋلاۋ مۇلدەم مۇمكىن بولمادى. ەلدىڭ ىشىندە ايقاي-شۋ, ۇرەي, قورقىنىش باستالدى. بۇل شەتەلگە شوپ-تۋر ەندى باستالىپ جاتقان جىلدار ەدى. سوندىقتان ءبىزدىڭ ۇكىمەت تە ۇندىستانمەن قارىم-قاتىناستى توقتاتۋ تۋرالى قاۋلى قابىلداۋعا ءماجبۇر بولدى.
جاسىراتىنى جوق, ول جىلدارى شەتەلگە شىعاتىندار نەگىزىنەن تاۋار, كيىم-كەشەك الىپ كەلەتىن. وسىلايشا ساۋدا-ساتتىق شارۋاسىمەن جۇرگەن قازاقستاننىڭ 70-كە جۋىق ازاماتى ءدال سول كەزدە ءۇندىستاندا قالىپ قويىپتى. ياعني سەس قىزمەتىنىڭ تىيىم سالعانىنا قاراماستان سول ەلگە بارىپ, بەرى قاراي شىعا الماي قالعان. ەندى نە ىستەۋىمىز كەرەك؟ ول كەزدە ورتالىق ازيا وباعا قارسى زەرتتەۋ ينستيتۋتى, قازىرگى ماسعۇت ايقىمباەۆ اتىنداعى اسا قاۋىپتى ينفەكتسيالار ۇلتتىق عىلىمي ورتالىعىنىڭ ديرەكتورى پروفەسسور ۆلاديمير ستەپانوۆ دەگەن كىسى ەدى. قازىر دە كوزى ءتىرى, جاسى سەكسەننەن استى, ەلگە ەڭبەگى سىڭگەن ازامات. مەن رەسپۋبليكالىق سەس-تە اسا قاۋىپتى جۇقپالى اۋرۋلار ءبولىمىنىڭ مەڭگەرۋشىسىمىن. سول ستەپانوۆ ەكەۋىمىز ەلىمىزدىڭ سىرتقى ىستەر مينيسترلىگىنە باردىق. ول كەزدە ءمينيستردىڭ ءبىرىنشى ورىنباسارى قاسىم-جومارت توقاەۆ بولاتىن. ءبىزدى سول كىسى قابىلدادى. ريزا بولعانىمىز –ورنىنان تۇرىپ, جىلى جۇزبەن قارسى الدى. شارۋامىزدى ايتتىق. اڭگىمە اراسىندا ينستيتۋتتىڭ عىلىمي جەتىستىكتەرى تۋرالى دا سۇرادى. سونىمەن ۇندىستانداعى ادامداردى الىپ كەلۋ ماسەلەسىن اقىلداستىق. بۇل كەڭەس وداعى جاڭادان تاراعان كەز. ەل ەكونوميكاسى ناشار, باياعى بايلانىستار جوق. ايتسە دە سىرتقى ىستەر مينيسترلىگى بۇل ماسەلەدەن حاباردار ەكەن. ءتىپتى ولاردىڭ اقپاراتى بىزگە قاراعاندا مولداۋ بولىپ شىقتى. ءبىز ءۇندىستاندا 70-كە جۋىق ازاماتىمىز قالىپ كەتتى دەپ جۇرسەك, ولاردىڭ سانى 114 ەكەن. سويتسەك, كەيبىر قازاقستاندىقتار شەكتەۋ قويىلعانىنا قاراماستان ء«ۇندىستاننىڭ ساۋدا ۇيلەرى ارنايى كۋرسقا شاقىرىپ جاتىر» دەگەن جالعان قۇجات تولتىرىپ, شەكارا اسىپ كەتە بەرىپتى. سونىمەن قاسىم-جومارت توقاەۆ بۇل ماسەلەنى جوعارعى جاققا بايانداپ, شەشەمىن دەپ ۋادە بەردى. شىنىندا توقاەۆ ۋادەسىندە تۇردى. ءبىر كۇننەن كەيىن ۇكىمەت ءبىر ۇشاقتى ۇندىستانعا جىبەردى. ايتپاقشى وسى تۇستا ءبىر قيىنشىلىق كولبەڭدەدى. العاشىندا بىردە-ءبىر ۇشقىش جانە ستيۋاردەسسا ىندەت تاراپ جاتقان ەلگە ۇشىپ بارۋعا كونبەدى. ويتكەنى ىندەت ادامدارعا اۋا ارقىلى تاراپ جاتقاندىقتان شىنىندا وتە قاۋىپتى ەدى. ۇشقىشتارمەن, ستيۋاردەسسالارمەن جەكە-جەكە سويلەستىك, تۇسىندىردىك, ۆاكتسينا ەكتىك. الىپ كەلەتىن ادامدار بۇل ىندەتتى جۇقتىرماعانىن ايتتىق. سونىمەن قىسقاسى, ەرتەڭىندە ۇشاق ۇندىستانعا بەت الدى. ول جاقتان كەلگەن ازاماتتاردى سەس, توتەنشە جاعداي, ءىىم قىزمەتكەرلەرى قارسى الىپ, ارنايى ءۇش اۆتوبۋسقا مىنگىزىپ, ماي كولىگى جول باستاپ, الماتى قالالىق جۇقپالى اۋرۋلار اۋرۋحاناسىنا الىپ كەلدىك. بارلىعى اۋرۋحانادا التى كۇن جاتىپ, دارىگەرلەردىڭ باقىلاۋىندا بولدى. پروفيلاكتيكالىق دارىلەر بەردىك. اللا جارىلقاپ, كوشىپ كەلۋشىلەردىڭ اراسىنان بىردە-ءبىر اۋرۋ تابىلعان جوق. ءسويتىپ ەل ۇكىمەتىنىڭ وسى ىسكە جاۋاپكەرشىلىكپەن قاراۋىنىڭ ارقاسىندا بۇل ىندەتكە ۋاقىتىندا توسقاۋىل قويىلدى. سونداي-اق بۇل ماسەلەنى قاسىم-جومارت كەمەل ۇلى ءوزىنىڭ باقىلاۋىندا ۇستاپ, ساتىمەن اياقتالۋىنا زور ۇلەس قوستى.
– ەلىمىزدە تاۋەلسىزدىكتىڭ كوك تۋى جەلبىرەگەن العاشقى جىلداردان-اق شەتەلدە جۇرگەن قانداستارىمىز ەلگە ورالا باستادى. شەكارادان بەرى وتكەن بۇل كوشتىڭ ەكپىنى سۇمدىق ەدى. ارينە, ەلگە ەل قوسىلسا – قۇت. دەگەنمەندە بۇل ىستە سانيتارلىق-ەپيدەميالىق جۇمىستار جاعى قالاي بولدى؟
– ءيا, 90-جىلداردىڭ باسىندا شەتەلدەگى قانداستار ەلگە كەلە باستادى. 1993 جىلى يراننان تۇركىمەنستان ارقىلى 4 مىڭ قازاقتى كوشىرىپ الىپ كەلۋ جۇمىسىنىڭ باسى-قاسىندا ءجۇردىم. بۇل كەزدە دە رەسپۋبليكالىق سەس-تە ءبولىم مەڭگەرۋشىسى ەدىم. سول جىلى بەس مارتە تۇركىمەنستانعا بارىپ, يران شەكاراسىنان بەرى وتكەن قانداستار اراسىندا جۇقپالى اۋرۋدىڭ بولماۋىن قاداعالادىم. ءالى ەسىمدە, شەكارادان بەرى وتكەن ءبىر قازاق جىگىت توقسانداعى اكەسىن ارقالاپ الىپتى. نەگىزى قاريانىڭ جولعا شىعۋىنا رۇقسات بەرمەۋىمىز كەرەك ەدى. ويتكەنى ءالسىز, اياق-قولى ىستەمەيدى, جولعا جارامايدى. كۇن وتە ىستىق. يران ەلىنىڭ اۋرۋحاناسىنا جاتقىزۋ قاجەت. بىراق بالاسى اكەسىن تاستاپ قالاي كەتەدى؟ قاريا جەتپىس جىل بويى تۋعان ەلىنە قايتۋدى ارمانداپتى. سونىمەن ەڭبەك, سىرتقى ىستەر مينيسترلىكتەرىنىڭ وكىلدەرى, ءبارىمىز اقىلداسىپ, رۇقسات بەردىك. بۇل شەشىمگە ولار قاتتى قۋاندى. اقساقالدىڭ بار ارمانى – تۋعان جەردىڭ توپىراعىن باسۋ ەدى. الايدا تۋعان جەرىن ءتىرى كورۋ قاريانىڭ ماڭدايىنا جازىلماپتى. يراننان تۇركىمەنستانعا وتكەن قانداستارىمىز اۆتوبۋسپەن «قىزىل اربات» ستانساسىنا جەتىپ, ءارى قاراي ەل ۇكىمەتى ارنايى جىبەرگەن پويىزعا وتىرۋى كەرەك ەدى. اۆتوبۋستا اقساقالدىڭ جۇرەگى شىداماي, بىرنەشە ساعاتتان كەيىن جولدا قايتىس بولدى. امال جوق, تۇركىمەنستاندا ءبىر قازاق اۋىلى بار ەكەن, كەشكە سول اۋىلدىڭ مولاسىنا جەرلەدىك. تاعى ءبىر ەسىمدە قالعانى اقساقال كوزى تىرىسىندە قاجىلىققا بارۋعا دەنساۋلىعى جاراماي, مەككەگە بارعان ادامدارعا قارجى بەرىپ, ءوز اتىنان قاجىلىق جاساتىپ, سول جاقتان اپپاق يحرام كيىمىن الدىرعان ەكەن. اقساقالدىڭ سوڭعى ءوتىنىشى بويىنشا مارقۇمدى سول كيىممەن جەرلەدىك. بۇل جولى دا قۇداي جارىلقاپ, يراننان كوشىپ كەلۋشىلەردىڭ اراسىنان بىردە-ءبىر جۇقپالى اۋرۋ جۇقتىرعاندار بولعان جوق. قانداستارىمىزدى دارىگەرلىك باقىلاۋعا الىپ, سىرقاتى بارلارىن ەمدەپ جازدىق.
سودان كەيىن 1996 جىلدىڭ قىركۇيەك ايىندا دەنساۋلىق ساقتاۋ مينيسترلىگى مەنى اياق استىنان موڭعولياعا جىبەردى. وسى ەلدەگى قانداستارىمىز كوشتىڭ باسىن بەرى قاراي بۇرعاندا موڭعوليادان تىرىسقاق اۋرۋى شىققان عوي. سونىمەن كوش توقتاپ قالعان. مينيسترلىك «كوشىپ كەلۋشىلەردى بارىپ كور, تەكسەر, جاعدايدى ءبىل, ماسەلەنى سول جەردە ءوزىڭ شەش, ەلگە جۇقپالى اۋرۋ وتپەسىن» دەدى. سودان الماتىدان وسكەمەنگە, ءارى قاراي بايان-ولگەيگە ۇشىپ باردىم. بارسام, اەروپورتتا قانشاما قازاق وشارىلىپ وتىر. ۇيلەرىن, دۇنيە-م ۇلىكتەرىن ساتىپ, جۇگىن جيناپ, قازاقستانعا كوشۋگە بەل بايلاعان قازاقتار عوي. ءبارى شاراسىز. ءبىزدىڭ ەلدەن بارعان ەكى سامولەت قاڭتارىلىپ تۇر. سونىمەن جەرگىلىكتى سەس-ءتىڭ ماماندارىمەن اقىلداستىم. نەگىزى ىندەت وشاعى باسقا وڭىردە ەكەن. سودان ويلانا كەلە كوشۋگە رۇقسات بەردىك. سەبەبى تىرىسقاق ارينە, اسا قاۋىپتى جۇقپالى اۋرۋ, بىراق, وعان قارسى ءبىزدىڭ ەلدىڭ دايىندىعى جاقسى ەدى. ءدارى-دارمەك جەتكىلىكتى. سونىمەن بۇكىل جاۋاپكەرشىلىكتى ءوز موينىما الىپ, رۇقسات بەردىم. كوشىپ كەلگەننەن كەيىن ورالمانداردى ءبىزدىڭ دارىگەرلەر بەس كۇن بويى قاداعالاۋعا الدى. قۇدايعا شۇكىر, ەشقانداي اۋرۋ شىقپادى.
– قايبىر جىلى قازاقستاندىقتاردى كونۆەرت ارقىلى تارايتىن ىندەت تە ءبىر شوشىتتى ەمەس پە؟
– ءيا, سونداي جاعداي بولعان. 2001 جىلى امەريكادا ايگىلى تەراكت ورىن الىپ, اسپانمەن تىرەسكەن ەكى بيىك عيمارات جەرمەن-جەكسەن بولعاننان كەيىن بۇل ەلدە كونۆەرتكە سالىنعان ۇنتاق تاراي باستادى. بۇل دا تەراكتىنىڭ ءبىر ءتۇرى بولسا كەرەك. ياعني قاسكوي بىرەۋلەر تۇينەمە, ءسىبىر جاراسىنىڭ شتامى بار ۇنتاقتى كونۆەرتكە سالىپ, اقش-تىڭ قۇزىرلى ورگاندارىنا جولداي باستاعان. كەيىننەن بۇل لابوراتوريالىق شتامم ەكەنى انىقتالدى. ايتپەسە, ونداي ۇنتاقتى ءۇي جاعدايىندا ىستەۋ مۇمكىن ەمەس. سودان امەريكا ابىگەرگە ءتۇسىپ جاتقاندا ءبىز دە قاراپ وتىرماي, ازىرلىكتى باستاپ كەتتىك. بارلىق وڭىرلەرگە «ازىرلىكتى كۇشەيتىڭدەر, وسىنداي جاعداي بىزدە دە بولۋى مۇمكىن» دەگەن حابار تاراتتىق. ايتقانداي ءبىر كۇنى الماتىداعى ءبىر بانكتەن كونۆەرتكە سالىنعان ۇنتاق تابىلدى دەگەن حابار ءتۇستى. بارساق, كەڭسەنىڭ ءبىر بولمەسىندە ەكى قىزمەتكەر كەلىنشەك وتىرادى ەكەن. سونىڭ ءبىرى جاڭا زەلانديادان كەلگەن ءبىر كونۆەرتتى ادەتتەگىدەي ءمان بەرمەستەن اشا سالعان عوي. ىشىنەن كوك ۇنتاق شىعىپتى. «قورىقپاڭىزدار, ءبارىن تەكسەرەمىز, بىراق, ءبارى انىقتالعانشا ۇيگە بارمايسىزدار, وقشاۋلاناسىزدار» دەپ, ەكەۋىن جۇقپالى اۋرۋلار اۋرۋحاناسىنا جاتقىزدىق. ءبىزدىڭ ماماندار كۇنى-ءتۇنى جۇمىس ىستەپ, تەكسەرۋ جۇمىستارىن ءبىر-ەكى كۇندە اياقتادى. ايتەۋىر, كونۆەرتتەن شىققان ۇنتاقتا ەشقانداي جۇقپالى اۋرۋلاردىڭ قوزدىرعىشتارى تابىلمادى. بىراق قاۋىپتى ۇنتاقپەن «قورقىتۋ» مۇنىمەن تىيىلمادى. سول جىلدارى الماتىنىڭ وزىندە وسىعان ۇقساس 60 شاقتى وقيعا تىركەلدى. كەيبىر ەرىككەندەر كىرەبەرىسكە ءارتۇرلى ۇنتاق توگىپ كەتىپ, ونى كورگەن تۇرعىندار قاتتى دۇرلىگىپ, بىزگە حابارلادى. بارلىق ۇنتاقتى تەكسەردىك, بىراق ەشقانداي جۇقپالى اۋرۋ انىقتالمادى.
ودان 2010 جىلى ورتالىق ازيا ەلدەرىندە بالالار اراسىندا پوليوميەليت كەڭىنەن تاراپ كەتتى. ءبىر وكىنىشتىسى, كورشى ەلدەردە ۆاكتسينا سالىنباعان 600-دەن استام بالاعا ءومىر بويى مۇگەدەك بولىپ قالدى. ءبىزدىڭ ەلدىڭ بالالارىن قوسىمشا ەگۋدىڭ ارقاسىندا بۇل قاۋىپتى اۋرۋعا شالدىققاندار بولعان جوق. بۇل جۇمىس ەلىمىزدىڭ بارلىق وڭىرىندە جەدەل ءجۇردى. حالىق جاس ۇرپاققا قاتەر ءتونىپ تۇرعانىن جاقسى ءتۇسىندى. ءسويتىپ 2010 جىلدىڭ 5-7 مامىر جانە 6-10 قىركۇيەگىندە 1 ملن 636 مىڭ بالاعا قوسىمشا ۆاكتسينا ەگىلدى. ياعني, 6 جاسقا دەيىنگى بالالاردىڭ 98,9 پايىزى قامتىلىپ, ەشقانداي توسىن جايتتار كەزدەسپەدى.
– راس بولسا قازاقستاندا كەزدەسەتىن كەيبىر اسا قاۋىپتى جۇقپالى اۋرۋلاردىڭ قوزدىرعىشى جۇزدەگەن جىلدارعا دەيىن ساقتالاتىن كورىنەدى.
– باسقاسىن قايدام, ءسىبىر جاراسىنىڭ قوزدىرعىشى ءجۇز جىلعا دەيىن توپىراقتا ساقتالادى. مۇنى اعىلشىن عالىمدارى دالەلدەگەن. سوندىقتان وسى ىندەتتەن ولگەن مالدى ورتەپ كومگەندە بەتىن بەتونداپ تاستايدى. ءسويتىپ ول ماڭدا مال جايىلماۋ كەرەك. مال قالاي اۋىرادى؟ كۇن ىستىق بولعاندىقتان ءشوپ كوتەرىلمەيدى, سوندىقتان مال كوكتى جەگەندە توپىراقتى ارالاستىرىپ جەپ, ەرنىن جارالاپ الادى. ال اۋرۋدىڭ قوزدىرعىشى سانداعان جىلدار بويى توپىراقتىڭ اراسىندا «سكافاندر» كيگەن كۇيىندە ساقتالىپ جاتادى. مالدىڭ ورگانيزمىنە تۇسكەننەن كەيىن «سىرتقى كيىمىن» شەشىنىپ, قاۋىپتى ميكروب رەتىندە قانعا تارالادى, وسەدى, كوبەيەدى. ءدال سول سياقتى قىرىم قاندى بەزگەگى دە وتە قاۋىپتى. كەزىندە قۇمنىڭ اراسىندا وتىرعان ەل كوكتەم شىعا نەگە جايلاۋعا كوشكەن؟ سەبەبى كۇن ىستىقتا قۇمدا كەنە, بۇرگە, تىشقاندار كوبەيەدى. دەنەسىندە ءتۇرلى اۋرۋلاردىڭ ۆيرۋسى بار كەنەلەر مالعا جابىسادى. مالدان ادامعا جۇعادى. ءالى ەسىمدە, 1989 جىلى جامبىل وبلىسى, سارىسۋ اۋدانىندا وسى ىندەت كوپ تاراپ كەتتى. جۇرت قوي قىرىققان. ءسويتىپ قىرىقتىقپەن ءجۇننىڭ اراسىنداعى كەنەنى دە قىرقىپ جىبەرىپ, ونىڭ قانى جۇققان. ەشقانداي زالالسىزداندىرۋ جۇمىستارى جۇرگىزىلمەگەن. وسىنىڭ سالدارىنان 72 ادام اۋىرىپ, 6-ۋى قايتىس بولدى. بۇل كەڭەس وكىمەتىندەگى ەڭ كوپ تاراعان اۋرۋ وشاعى بولعاندىقتان حالىق قاتتى ۇرەيلەندى. جالپى سوڭعى 20-30 جىلدا شەتەلدەن شىققان جۇقپالى اۋرۋلاردىڭ ءبىزدىڭ ەلگە ءسىڭىپ كەتكەنىن بىلمەيمىن. 2003 جىلى اتيپتىك پنەۆمونيا, 2005 جىلى قۇس تۇماۋى, 2009 جىلى شوشقا تۇماۋى, ەبولا, زيكا اۋرۋلارىنا قارسى ءبىرتالاي شارالار قولعا الىندى. جالپى ءبىز دۇنيە جۇزىندەگى جۇقپالى اۋرۋلارعا قارسى كۇرەسۋ تاسىلدەرىن ءبىلىپ, سوعان ءاردايىم دايىن بولۋىمىز قاجەت. ەڭ باستىسى – ءوز ولكەسىندە قانداي جۇقپالى اۋرۋلار بار ەكەنىن جەرگىلىكتى تۇرعىنداردىڭ ءوزى جاقسى ءبىلۋى كەرەك. سونى جەتكىزۋ ءبىزدىڭ مىندەتىمىز.
– ايتپاقشى, قايبىر جىلى قىرىم قاندى بەزگەگى تۇركىستاندىقتاردىڭ دا ۇرەيىن ۇشىردى ەمەس پە؟
– بۇل وقيعا 2009 جىلى بولدى. قازىر حالىقتىڭ جەكە باسىنىڭ گيگيەناسىن ساقتاۋ مادەنيەتى جوعارى عوي. دەگەنمەندە ءار ۋاقىتتا بىلمەستىك, بەيعامدىق قۇرتادى. 2009 جىلى تۇركىستاندىق 4 دارىگەر جانە جۇكتى ايەل بالاسىمەن قىرىم قاندى بەزگەگىن جۇقتىرىپ قايتىس بولدى. ياعني, اۋرۋحانادا جاتقان ەكىقابات ايەل ءوزىنىڭ قاۋىپتى ىندەتتى جۇقتىرىپ العانىن بىلمەگەن. ناتيجەسىندە بوساندىرىپ الۋعا كىرىسكەن دارىگەرلەر دە ىندەتتى جۇقتىرىپ, سوڭى قايعىلى اياقتالدى.
اڭگىمەلەسكەن
ورالحان ءداۋىت,
«Egemen Qazaqstan»






































